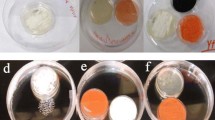

Abstract
The recently identified causative agent of white-nose syndrome (WNS), Pseudogymnoascus destructans, has been implicated in the mortality of an estimated 5.5 million North American bats since its initial documentation in 2006 (Frick et al. in Science 329:679–682, 2010). In an effort to identify potential biological and chemical control options for WNS, 6 previously described bacterially produced volatile organic compounds (VOCs) were screened for anti-P. destructans activity. The compounds include decanal; 2-ethyl-1-hexanol; nonanal; benzothiazole; benzaldehyde; andN,N-dimethyloctylamine. P. destructans conidia and mycelial plugs were exposed to the VOCs in a closed air space at 15 and 4 °C and then evaluated for growth inhibition. All VOCs inhibited growth from conidia as well as inhibiting radial mycelial extension, with the greatest effect at 4 °C. Studies of the ecology of fungistatic soils and the natural abundance of the fungistatic VOCs present in these environments suggest a synergistic activity of select VOCs may occur. The evaluation of formulations of two or three VOCs at equivalent concentrations was supportive of synergistic activity in several cases. The identification of bacterially produced VOCs with anti-P. destructans activity indicates disease-suppressive and fungistatic soils as a potentially significant reservoir of biological and chemical control options for WNS and provides wildlife management personnel with tools to combat this devastating disease.
Similar content being viewed by others
Avoid common mistakes on your manuscript.
Introduction
White-nose syndrome (WNS) was first documented near Albany, New York, in 2006 [2, 15]. Since its discovery, WNS has caused severe declines in bat populations in the Eastern United States and Canada [9, 12, 23]. Although the exact ecological and economic impact of this disease has yet to be determined, many researchers agree that continued declines in insectivorous bat populations will have a significant impact on forest management, agriculture and insect-borne disease [4]. The rapid spread of WNS and the high mortality rates associated with the disease [9, 13] necessitate the rapid development of disease management tools. In 2011, the fungus Geomyces destructans was shown to be the putative causative agent of WNS [18].
Recently, the fungus Geomyces destructans has been reclassified as Pseudogymnoascus destructans [19, 20]. P. destructans is a psychrophilic ascomycete with optimal growth at 12.5–15.8 °C [15, 23]. Its psychrophilic nature makes P. destructans ideally suited for colonization of bats in torpor, when body temperatures and immune function are greatly depressed [3, 5]. The clinical manifestation of P. destructans infection is characterized by fuzzy white growth on the muzzle and wings of hibernating bats and results in severe physical damage to bat wing membranes [8]. Due to the recent identification of P. destructans, many ecological and physiological traits and their influence on virulence are yet to be elucidated.
The rapid spread and high mortality rates associated with WNS make the development of in situ treatment options for P. destructans a significant objective for wildlife management agencies. Accordingly, the development of biological and chemical treatment options is a priority for State and Federal agencies as stated in the 2011 National WNS Management Plan established by the United States Fish and Wildlife Service (USFWS) [1]. With this goal in mind, 6 previously described bacterially produced antifungal VOCs [7, 11] were assayed for their in vitro potential to inhibit the growth and proliferation of P. destructans.
Previous investigations of fungistatic soils were able to identify bacteria that produced antifungal VOCs which were later identified via SPME/GC/MS of cultures and soils. The VOCs were produced by Pseudomonas and Bacillus spp. and demonstrated broad spectrum antifungal activity [7, 11]. Volatile-based fungistasis in soils has been observed in terrestrial environments around the globe [25]. Due to the biological and chemical complexity of these environments, the ultimate source of the active VOCs is often unknown but typically attributed to bacteria [16, 25]. The geology and ecology of soil make the presence of inhibitory volatiles of particular interest, as low levels of VOCs are able to inhibit fungal growth in a dense, compartmentalized, and diverse ecosystem [10, 11, 14, 16]. Using the soil ecosystem as an ideal example of naturally occurring biological control of fungal proliferation, we began to investigate biologically derived VOCs with known antifungal activity.
The influence of the VOCs on the growth from conidia and mycelial extension of P. destructans was evaluated using digital imaging techniques. In an effort to optimize the efficacy of the VOCs for potential in situ applications, formulations of VOCs were evaluated for potential synergistic effects. Combinations of two VOCs applied at equal quantities as individual VOCs revealed several potentially synergistic combinations. Accordingly, these synergistic blends were used to establish formulations of three VOCs ultimately yielding highly effective formulations with greatly increased anti-Pseudogymnoascus activity at relative concentrations of <1 ppm. The identification of biologically produced inhibitory volatiles expands the pool of potential biocontrol agents of P. destructans, and the development of chemical formulations with significant anti-Pseudogymnoascus activity at low concentrations provides promising chemical control options for in situ management of WNS.
Materials and Methods
Culture Acquisition and Maintenance
All P. destructans isolates used in the project were provided by Kevin Keel through his WNS diagnostic work at the University of Georgia’s Southeastern Cooperative Wildlife Disease Study (SCWDS). P. destructans cultures were maintained on Sabauroud Dextrose Agar (SDA) or in Sabauroud Dextrose Broth (SDB) (BD, Maryland) at 4–15 °C. P. destructans spores were stored in phosphate-buffered saline (PBS) at −20 °C. Spores were stored no longer than 3 weeks prior to use.
VOC Exposure Assays and Evaluation of Bacterially Produced VOCs for Anti-P. destructans Activity
Volatile organic compounds previously shown to be produced by bacteria [7, 11] were screened for anti-P. destructans activity via VOC exposure to spores and mycelial plugs. The VOCs included: decanal; 2-ethyl-1-hexanol; nonanal; benzothiazole; benzaldehyde; and N,N-dimethyloctylamine (Sigma-Aldrich, Missouri). All VOCs were chosen based on their identification in fungistatic soils and their observed production in bacteria [7, 11]. All VOCs purchased as pure, liquid, research grade reagents and used directly, without modification, in all subsequent assays. A single-compartment Petri plate (150 mm × 15 mm) was used for a contained airspace to assess P. destructans growth characteristics in the presence of fungistatic VOCs. Ten microliters of P. destructans conidia suspension (106 conidia ml−1 in PBS) was spread onto SDA plates (35 mm × 10 mm). Aliquots of 30, 3.0, or 0.3 μl of each VOC corresponding to maximum possible relative concentrations ranging from 113 ppm (v/v) to 1.13 ppm (v/v) (Table S1) were pipetted onto a sterile filter paper disk (12.7 mm) on a watch glass (75 mm). Each VOC containing disk and watch glass was placed inside a large Petri plate (150 mm × 15 mm) along with a P. destructans-inoculated SDA plate (35 mm × 10 mm) (Fig. 1). P. destructans mycelial plugs cut from the leading edge of actively growing colonies were inserted into fresh SDA plates (35 mm × 10 mm) and placed in large Petri plates (150 mm × 15 mm) with each formulation or pure VOC containing paper disk and sealed with parafilm M (Sigma-Aldrich, Missouri). Plates were then incubated at 15 °C for 21 days. Unexposed cultures and the addition of activated carbon to exposure assays served as negative controls for each trial. Anti-P. destructans activity was scored on a plus/minus scale for conidia-inoculated plates, and the radial growth from mycelial plugs was used to determine percent inhibition by comparing growth area of VOC exposed plugs to unexposed controls. All assays were performed in triplicate and averaged.
VOC Formulation Assay for Anti-P. destructans Activity
VOC formulations utilizing combinations of two pure VOCs were created with all fifteen possible combinations of the six VOCs by applying volumes corresponding to 2.0 μmol of each VOC to separate absorbent disks and arranging combinations of two disks of different VOCs on a single watch glass. Volumes corresponding to 4.0 μmol of each pure VOC were used as synergism controls to determine synergism. P. destructans mycelial plugs were harvested and inserted into fresh SDA plates (35 mm × 10 mm) and sealed with parafilm in large Petri plates (150 mm × 15 mm) with each formulation or pure VOC. Plates were then incubated at 15 °C for 21 days as described above. Each test was conducted in triplicate. Area measurements were conducted every 2 days post-inoculation with the use of digital photography and computer analysis as described below.
Area Measurement of Radial Growth with Digital Photography and Open-Source Software
Filamentous fungi grow by hyphae elongation and not by distinct cellular division. Accordingly, measuring the difference between the area growth of control agent-exposed mycelial plugs and control plugs has been a vetted method for assessing antimicrobial susceptibility [11, 17, 22]. The use of a ruler to measure the area of mycelial growth of filamentous fungi has its own challenges. Mycelial plugs will often grow asymmetrically, either naturally or because of exposure to the compound being tested. To provide more accurate measurement of mycelial growth, a digital photography and analysis technique was developed.
The GIMP (GNU Image Manipulation Program) is open-source, freely distributed software for image editing and authoring, compatible with GNU/Linux, Microsoft Windows, Mac OS X, Sun OpenSolaris, and FreeBSD operating systems. This software allows for the direct measurement of the number of pixels in a given selected area of a photograph. GIMP version 2.8.2 for Microsoft Windows was used at the time of this writing. A Nikon D3100 digital single lens reflex camera with an 18–55 mm lens was used to capture images. A standard three-leg tripod was used for support during capture.
The camera was attached to the tripod and aimed down to a surface to provide a consistent distance from the lens to the mycelial surface being photographed; ensuring the same pixel to millimeter ratio was retained for all acquired images. Images of mycelial plugs had their corresponding image numbers catalogued for later identification. All Petri plate agar heights were similar to ensure the focal point remained consistent as well as to retain the same pixel to distance ratio. Manual focus was activated to retain the same focal point throughout all image captures, and a remote shutter release device was used to assure stable, shake-free images were acquired.
Contrast between the growth medium and mycelium was required to obtain an accurate selection for measurement as well as to be able to discern the margin of the ruler graduation marks with GIMP. Therefore, the camera’s white balance, exposure, f-stop, and ISO were adjusted to retain a consistent contrast between photograph acquisitions. A photograph of a ruler was used to set the focal point for the proceeding photographs as well as serving as a calibration device for determining the length of each pixel during image analysis.
The ruler tool was used to determine the number of pixels between two demarcations of a photographed ruler placed at the level of the agar surface in the Petri plates. The resulting pixel count was used to determine the millimeter-to-pixel ratio.
A different set of tools were necessary to measure the mycelial area. The selection tools were used to outline the margin of the mycelia. The Histogram tool was used to determine the number of pixels that comprised the selected area. The area of the selection was converted from the number of pixels to mm2 with our previously derived number of pixels per mm and Eq. 1.
Tape Mount Preparation and Microscopic Evaluation
Pseudogymnoascus destructans cultures with aberrant phenotypes as compared to control cultures and published descriptions [14] were examined microscopically by tape mount. The adhesive side of standard transparent packaging tape was gently pressed against the surface of plate grown fungal colonies. The resulting tape-adhered sample was treated with 10 μl of 70 % ethanol and placed onto a microscope slide with lactophenol cotton blue dye. Slides were viewed on a light microscope (Nikon optiphot-2) at 200 × magnification and images captured using a scope mounted camera (QImaging micropublisher 3.3 RTV).
Results
Anti-P. destructans Activity of Bacterially Produced Volatiles
Initial investigation demonstrated inhibitory activity for most VOCs at relative concentrations less than 1 ppm. Decanal; 2-ethyl-1-hexanol; nonanal; benzothaizole; dimethyltrisulfide; benzaldehyde; and N,N-dimethyloctylamine all demonstrated anti-P. destructans activity when 30 μl of the respective compound were placed adjacent to SDA plates inoculated with P. destructans conidia in a closed system at 15 °C (Table 1). Control plates containing 1 g activated carbon showed no inhibition for decanal; 2-ethyl-1-hexanol; and benzaldehyde, while the remaining compounds inhibitory activity persisted in the presence of activated carbon (Table 1). Subsequent assays with 3 μl of each compound demonstrated similar results with only N,N-dimethyloctylamine unable to completely inhibit P. destructans growth from conidia at 7 days (Table 1). The addition of activated carbon abolished all inhibitory activity of the assayed compounds at 3 μl (Table 1). At 11 days of exposure to 3 μl of each respective compound, only 2-ethyl-1-hexanol, decanal, and nonanal demonstrated inhibitory activity, with all activated carbon controls abolishing the inhibitory activity (Table 1). Additionally, P. destructans cultures from conidia exposed to 3 μl benzothiazole without activated carbon revealed unique colony morphology characterized by increased pigmentation of the underside of the culture and diffusion of pigment into the growth media as compared to unexposed cultures and cultures exposed to benzothiazole in the presence of activated carbon (Fig. S1).
Assays using mycelial plugs cut from the leading edge of actively growing P. destructans colonies on SDA exposed to the previously described bacterially produced volatiles at 30, 3, and 0.3 μl of each respective compound and incubated in a contained air space at 15 °C gave varied results. At 30 μl, all compounds completely inhibited the growth of P. destructans mycelia for up to 9 days (Fig. 2a). At 14 days of exposure, only P. destructans plugs exposed to decanal showed any radial growth, with 83 % reduction in growth as compared to unexposed controls (Fig. 2a). At 3 μl of each compound, decanal and N,N-dimethyloctylamine yielded only minor reductions in radial growth, whereas the remaining compounds completely inhibited radial mycelial growth of P. destructans for up to 14 days (Fig. 2b). At 0.3 μl of each compound, only benzothiazole demonstrated significant inhibitory activity with a 60 % reduction in radial growth after 14 days of exposure (Fig. 2c). Interestingly, at 0.3 μl, N,N-dimethyloctylamine induced growth as compared to unexposed controls (Fig. 2c). This result may be due to hormesis [21].
Growth areas of P. destructans mycelial plugs exposed to bacterially produced VOCs at 15 °C at 30 μl (a), 3 μl (b), 0.3 μl (c), respectively. Growth area of mycelial plugs exposed at 4 °C to 0.3 μl (d) of bacterially produced VOCs. VOCs not shown in the legend completely inhibited radial growth for the duration of the experiment
In order to forecast the in situ efficacy of the VOCs additional in vitro evaluation was conducted at 4 °C to more accurately represent the environmental conditions of North American hibernacula. Exposure to 30 μl or 3.0 μl of each respective VOC completely inhibited radial growth of P. destructans for greater than 21 days (data not shown). Exposure to 0.3 μl of each respective VOC inhibited radial growth for all VOCs except benzaldehyde (Fig. 2d). The greatest degree of inhibition was observed with decanal which demonstrated a greater than 99 % reduction in growth area at 35 days post-inoculation (Fig. 2d). Based on these initial results, VOC exposure was standardized to 4.0 μmol per headspace for subsequent evaluations. In addition to evaluating individual VOCs, formulations were investigated for potential synergistic effects.
VOC Formulations Demonstrate Synergistic Anti-P. destructans Activity
Three VOC formulations comprised of two VOCs were observed to synergistically inhibit the growth of P. destructans mycelial plugs, more than the combined inhibition of each of the pure VOCs alone. Those include 2-ethyl-1-hexanol and benzaldehyde; 2-ethyl-1-hexanol and nonanal; 2-ethyl-1-hexanol and decanal; and 2-ethyl-1-hexanol and N,N-dimethyloctylamine (Fig. 3a, 3b, 3c, respectively). The greatest inhibition by the formulation occurred with 2-ethyl-1-hexanol and nonanal, which demonstrated greater than 95 % reduction in growth as compared to unexposed controls 14 days post-inoculation (Fig. 3c).
Two VOC formulations comprised of three VOCs at 1.33 μmol, respectively, were observed to synergistically inhibit the growth of P. destructans mycelial plugs, more than the combined inhibition of each of the pure VOCs alone at 4.0 μmol. Those include 2-ethyl-1-hexanol; benzaldehyde; and decanal; as well as 2-ethyl-1-hexanol; nonanal; and decanal (Fig. 4a, 4b).
Discussion
Since its initial documentation in 2006, P. destructans has spread to twenty-four states and four Canadian providences and is implicated in the mortality of 5.5 million bats [13]. Cave closures and culling of infected individuals appear to have little to no impact on the spread and mortality associated with this devastating disease. Classic disease management practices applied in agriculture such as broad spectrum dissemination of antibiotics are not realistic options for management of disease in wild, highly disseminated, and migratory animal populations. Accordingly, the development of novel treatment options is needed to avert the spread of this disease and reduce the mortality associated with currently infected hibernacula. To this end, the evaluation of previously described bacterially produced antifungal volatiles was conducted to identify potential chemical control agents as well as identify potential environmental reservoirs of anti-P. destructans activities and expand the pool of potential biological control agents.
Bacterially derived volatile fungistasis is a well-documented microbial antagonism and may be common in terrestrial ecosystems [7, 10, 11, 14, 16, 25]. Harnessing the potential of these natural antagonisms is already a powerful tool in the development of highly effective biological and chemical control options [7, 11, 17]. The biological origin of many fungistatic VOCs lends itself to obtainable inhibitory applications due to the typically low level of production in the natural hosts and the significant antagonistic activity observed at these low levels [7, 10, 14, 16, 21, 24]. The contact-independent activity of antagonistic VOC has several advantages over topical and oral, contact-dependent, treatment options that have been shown to be highly effective at inhibiting the growth of P. destructans in previous studies [6]. Contact-independent antagonisms allow for treatment of many individuals with a single application and ensure uniform exposure, avoiding the potential for microbial refugia on the host that may facilitate re-colonization of the host once the inhibitory compound has been removed or degraded. Accordingly, the evaluation of previously described bacterially produced VOCs reduces the processing required to identify viable treatment options, and the contact-independent activity of antagonistic VOCs has several advantages over topical and oral antifungal compounds and should be a focus of studies tasked with identifying novel treatments for newly emerging fungal diseases.
The coevolution of soil microbiota has produced antagonisms ideally suited for the complex ecology of soil. Harnessing these natural antagonisms can be a powerful tool in combating WNS as many of the traits of these antagonisms equate favorably with the ecology of hibernacula and the terrestrial heritage of the Geomycota and Pseudogymnoascus spp. warrants their susceptibility. The long-term efficacy of low quantities of VOCs illustrates the potential of these compounds for in situ application in the treatment of WNS. Additionally, the development of synergistic blends bolsters the appeal of soil-based fungistasis as a source of potential control agents as VOC mixtures are likely responsible for the observed fungistatic activity of repressive soils [14, 16, 24]. While several pure VOCs and blends produced significant growth inhibition, compounds and/or quantities unable to significantly inhibit growth caused noteworthy stress to P. destructans as determined by the abnormal phenotypes observed under these conditions (Fig. S1). The evaluation of bacterially derived VOCs has expanded the pool of potential biological control agents as well produced several VOC formulations with excellent anti-Pseudogymnoascus activity. The availability of volatile formulations for control of P. destructans growth could prove to be a powerful tool for wildlife management agencies if appropriate application methods can be developed.
Current technology for dissemination of VOCs and essential oils for control of odors and pests in indoor environments is common with several companies, including TimeMisttm, Aire-Mastertm, Prolitectm and Air-Scenttm actively marketing these systems. Manufacturers claims vary significantly depending on product with treatment capacities varying from 6,000 to 50,000 ft3 for a single unit and maintain 1–10 ppm concentrations in that area based on timed releases with various product lines. Although these claims are promising, appropriate scientific validation is lacking. Fragrance dispenser systems are compatible with a wide range of VOC and essential oils and their efficacy claims warrant further investigation as a potential application method for anti-Pseudogymnoascus VOCs in the treatment of WNS in hibernating bats.
The ecology of susceptible bat populations makes treatment of WNS difficult. The highly dispersed, difficult to access, and potentially hazardous nature of bat hibernacula require the development of control options with persistent inhibitory activity at low levels. Our results indicate a strong inhibitory activity for several compounds and have provided valuable leads for identification of potential biological control agents. The increased inhibitory effect observed in low temperature (4 °C) exposures is promising for field application as they represent a promising duration at the low temperatures associated with hibernacula during the time of infection and could have a significant impact on the mortality associated with infected hibernacula. Currently, the prognosis for susceptible North American bat populations is bleak at best. The development of biological and chemical treatment options must be investigated to provide wildlife management agencies with tools for control of P. destructans transmission and infectivity.
This project identified biologically derived chemical control agents that can potentially disrupt transmission by inhibiting growth from conidia as well as decrease infection/mortality rates in hibernacula currently infected with P. destructans. Additionally, several of the compounds evaluated in this study have the potential for application in captive-recovery programs purposed in the National Response Plan [1]. Cumulatively, this study has highlighted potential control options for further investigation for application in management of WNS as well as identified fungistatic soils as a potentially significant reservoir of biological control agents.
References
Ballman A, Benedict L, Britzke E, Castle K, Cottrell W, Cryan P, DeLiberto T, Elliot A, Ewing R, Hicks A, Reynolds R, Rubado J, Slack B, Williams L, Coleman J. A national plan for assisting states, federal agencies, and tribes in managing white-nose syndrome in bats. 2011: whitenosesyndrom.org.
Blehert DS, Hicks AC, Behr M. Bat white-nose syndrome: an emerging fungal pathogen? Science. 2008;323:227.
Boyles JG, Willis C. Could localized warm areas inside cold caves reduce mortality of hibernating bats affected by white-nose syndrome? Front Ecol Environ. 2010;8:92–8.
Boyles JG, Cryan PM, McCracken GF, Kunz TH. Economic importance of bats in agriculture. Science. 2011;332:41–2.
Casadevall A. Fungal virulence, vertebrate endothermy, and dinosaur extinction: is there a connection? Fungal Genet Biol. 2005;42:98–106.
Chaturvedi S, Rajkumar SS, Li X, Hurteau GJ, Shtutman M, Chaturvedi V. Antifungal testing and high-throughput screening of compound library against Geomyces destructans, the etiologic agent of Geomycosis (WNS) in bats. PLoS ONE. 2011;6:e17032. doi:10.1371/journal.pone.0017032.
Chuankun X, Minghe M, Leming Z, Keqin Z. Soil volatile fungistasis and volatile fungistatic compounds. Soil Biol Biochem. 2004;36:1997–2004.
Cryan P, Meteyer CU, Boyles J, Blehert DS. Wing pathology of white-nose syndrome in bats suggests life threatening disruption of physiology. BMC Biol. 2010;8:135.
Cryan P. White-nose syndrome threatens the survival of hibernating bats in North America. In: USGS Fort Collins Science Center. 2011. Retrieved 21 Apr 2012.
Ezra D, Strobel GA. Effect of substrate on the bioactivity of volatile antimicrobials produced by Muscodor albus. Plant Sci. 2003;165:1229–38.
Fernando WGD, Ramarathnam R, Krishnamoorthy AS, Savchuk SC. Identification and use of potential bacterial organic antifungal volatiles in biocontrol. Soil Biol Biochem. 2005;37:955–64.
Frick WF, Pollock JF, Hicks AC, Langwig KE, Reynolds DS, Turner GG, Butchkoski CM, Kunz TH. An emerging disease causes regional population collapse of a common North American bat species. Science. 2010;329:679–82.
Froschauer A, Coleman J. North American bat death toll exceeds 5.5 million from white-nose syndrome. U.S. Fish and Wildlife Service; 2012. http://www.batcon.org/pdfs/USFWS_WNS_Mortality_2012_NR_FINAL.pdf
Garbeva P, Hol WHG, Termorshuizen AJ, Kowalchuk GA, Boer WD. Fungistasis and general soil biostasis—a new synthesis. Soil Biol Biochem. 2001;43:469–77.
Gargas A, Trest MT, Christensen M, Volk TJ, Blehert DS. Geomyces destructans sp. nov., associated with bat white-nose syndrome. Mycotaxon. 2009;108:147–54.
Kerr JR. Bacterial inhibition of fungal growth and pathogenicity. Microb Ecol Health Dis. 1999;11:129–42.
Liu W, Mu W, Zhu B, Liu F. Antifungal activities and components of VOCs produced by Bacillus subtilis G8. Curr Res Bacteriol. 2008;1:128–34.
Lorch JM, Meteyer CU, Boyles JG, Cryan P, Hicks AC, Ballman AE, Coleman JTH, Redell DN, Reeder DM, Blehert DS. Experimental infection of bats with Geomyces destructans causes white-nose syndrome. Nature. 2011;480:376–8.
Lorch JM, Lindner DL, Gargas A, Muller LK, Minnis AM, Blehert DS. A culture-based survey of fungi in soil from bat hibernacula in the eastern United States and its implications for detection of Geomyces destructans, the causal agent of bat white-nose syndrome. Mycologia. 2013;105:237–52.
Minnis AM, Linder DL. Phylogenetic evaluation of Geomyces and allies reveals no close relatives of Pseudogymnoascus destructans, comb. nov., in bat hibernacula of eastern North America. Fungal Biol. 2013. http://dx.doi.org/10.1016/j.funbio.2013.07.001.
Stebbing ARD. Hormesis: the stimulation of growth by low levels of inhibitors. Sci Total Environ. 1982;22:213–34.
Strobel GA, Kluck K, Hess WM, Sears J, Ezra D, Vargas PN. Muscodor albus E-6, an endophyte of Guazuma ulmifolia making volatile antibiotics: isolation, characterization and experimental establishment in the host plant. Microbiology. 2007;153:2613–20.
Turner GG, Reeder DM, Coleman JTH. A five-year assessment of mortality and geographic spread of white-nose syndrome in North American bats and a look to the future. Bat Res News. 2011;52:13–27.
Verant ML, Boyles JG, Waldrep W, Wibbelt G, Blehert DS. Temperature-dependent growth of Geomyces destructans, the fungus that causes bat white-nose syndrome. PLoS ONE. 2012;7:e46280. doi:10.1371/journal.pone.0046280.
Zou CS, Mo ME, Gu YQ, Zhou JP, Zhang KQ. Possible contributions of volatile-producing bacteria to soil fungistasis. Soil Biol Biochem. 2007;39:2371–9.
Acknowledgments
This work was funded by the Georgia State University Department of Biology, as well as the Georgia State University Environmental Research Program. The authors would like to thank Kevin Keel for providing the fungal cultures used in this study. The authors would also like to thank Ian Sarad, Blake Cherney, and Ben Poodiak for their contributions to this effort.
Author information
Authors and Affiliations
Corresponding author
Electronic supplementary material
Below is the link to the electronic supplementary material.
Rights and permissions
About this article
Cite this article
Cornelison, C.T., Gabriel, K.T., Barlament, C. et al. Inhibition of Pseudogymnoascus destructans Growth from Conidia and Mycelial Extension by Bacterially Produced Volatile Organic Compounds. Mycopathologia 177, 1–10 (2014). https://doi.org/10.1007/s11046-013-9716-2
Received:
Accepted:
Published:
Issue Date:
DOI: https://doi.org/10.1007/s11046-013-9716-2